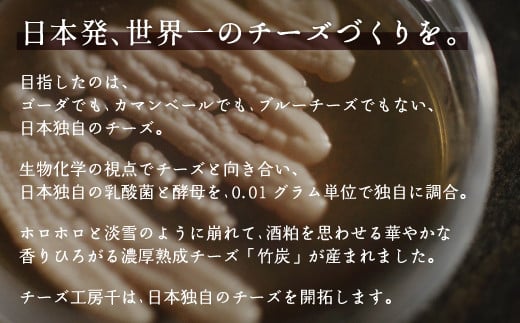

新規会員登録
C01901 千の便り
チーズ3種とホエイドレッシングのセット
〇 在庫あり
寄付金額:
19,000
円
数量:
この返礼品について
この返礼品の詳細情報
返礼品名
C01901 千の便り
返礼品コード
C096-5695761
寄付金額
寄付金額:
19,000
円
支払方法
全額ポイント
クレジットカード決済
内容量
チーズ3種
・竹炭濃厚熟成 100g
・季節の熟成チーズ 100g
・塩麹漬け 25g
ホエイドレッシング 120g
・竹炭濃厚熟成 100g
・季節の熟成チーズ 100g
・塩麹漬け 25g
ホエイドレッシング 120g
配送温度帯
冷蔵
配送方法
【配送業者】ヤマト
【別送対応】対応可能
【別送対応】対応可能
提供事業者
チーズ工房【千】sen
発送時期
【2024年末~2025年 配送スケジュール】
・2024/11/25~2025/1/26寄附分 →1/31(金)配送
・1/27~2/23寄附分 →2/28(金)配送
・2/24~3/30寄附分 →4/4(金)配送
・3/31~4/27寄附分 →5/2(金)配送
・4/28~5/25寄附分 →5/30(金)配送
・5/26~6/29寄附分 →7/4(金)配送
・6/30~7/27寄附分 →8/1(金)配送
・7/28~8/31寄附分 →9/5(金)配送
・9/1~9/28寄附分 →10/3(金)配送
・9/29~10/26寄附分 →10/31(金)配送
・10/27~11/30寄附分 →12/5(金)配送
・2024/11/25~2025/1/26寄附分 →1/31(金)配送
・1/27~2/23寄附分 →2/28(金)配送
・2/24~3/30寄附分 →4/4(金)配送
・3/31~4/27寄附分 →5/2(金)配送
・4/28~5/25寄附分 →5/30(金)配送
・5/26~6/29寄附分 →7/4(金)配送
・6/30~7/27寄附分 →8/1(金)配送
・7/28~8/31寄附分 →9/5(金)配送
・9/1~9/28寄附分 →10/3(金)配送
・9/29~10/26寄附分 →10/31(金)配送
・10/27~11/30寄附分 →12/5(金)配送
注意事項
【申込期日】
通年
通年
ご注文に関する注意事項
【アレルギー品目】
乳成分
乳成分
【申込条件】何度も申込可